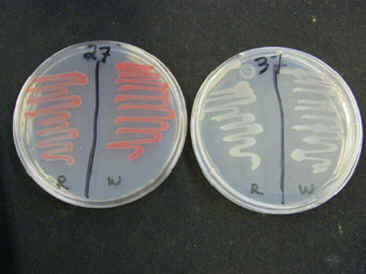

Tour of Microbes  Tour Home | Disease Home | Microbes A to Z | Bio 203 Home |

Serratia are Gram-negative rods belonging to the Enterobacteria. They are common to soil, water, and mammals. S. marcescens is an opportunistic pathogen in humans and is easily recognized by its large, red-pigmented colonies when grown at less than 35C. At 37C, however, the genes for making the red pigment prodigiosin are turned off.
gamma-proteobacteria (volume 2)
Facultative anaerobe, respiratory and fermentative metabolism, oxidase-negative, catalase-positive, H2S-negative, indole-negative, citrate-positive, casease-positive, DNAse-positive, amylase-negative, non-motile, nitrate-negative